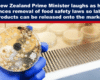

Before the UK general elections, The Guardian published an article accusing members of Reform UK of promoting “conspiracy theories.” One such “theory” was chemtrails. Embarrassingly for The Guardian, just a couple of […]


Before the UK general elections, The Guardian published an article accusing members of Reform UK of promoting “conspiracy theories.” One such “theory” was chemtrails. Embarrassingly for The Guardian, just a couple of […]

As part of the upcoming film ‘CBDC: The End of Money’, Big Picture’s James Patrick interviewed renowned economist and professor Richard Werner. There are three different theories about how banks operate: Financial […]

A group of health professionals have expressed concern to the General Medical Council (“GMC”) about the use of GMC referrals against doctors speaking out about the safety of the covid-19 injections. They […]

Abandoning longstanding ethical principles, the Royal College of Nursing in the UK has issued new guidelines that justify refusal to treat or withdrawal of care in cases of discriminatory behaviour, including racism. […]
Last week in New Zealand, Judith Collins, Minister for Science and Technology, and Chris Luxon, Prime Minister, decided to introduce a policy change with a Laurel and Hardy double act on Twitter; it was […]

It feels like we can’t go a single week without hearing about the re-emergence, or emergence of a disease or ailment at the moment. We’ve had a mysterious outbreak of hepatitis among […]

We are witnessing the confluence of carefully implemented legislation, judicial and enforcement mechanisms combined with hyper-effective PsyOp manipulation through fake media, Ignasz Semmelweisz writes and uses images from various sources to explain […]